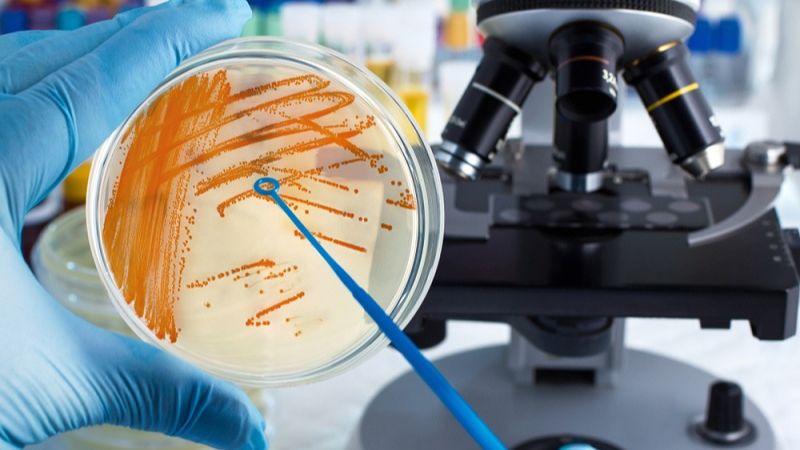
Tìm hiểu một số môi trường nuôi cấy vi khuẩn 2

Dược sĩ Đại học có nhiều năm kinh nghiệm trong việc tư vấn Dược phẩm và hỗ trợ giải đáp thắc mắc về Bệnh học. Hiện đang là giảng viên cho Dược sĩ tại Nhà thuốc Long Châu.
Thùy Hương
04/05/2024
Mặc định
Lớn hơn
Nuôi cấy vi khuẩn là phương pháp xác định nhiều bệnh nhiễm trùng. Tuy nhiên, lựa chọn được môi trường nuôi cấy vi khuẩn phù hợp không đơn giản. Tham khảo ngay!
Ngày nay, việc chẩn đoán các bệnh nhiễm trùng thông qua xét nghiệm vi sinh là không thể thiếu. Trong số các phương pháp phổ biến và dễ áp dụng tại các cơ sở y tế, kỹ thuật nuôi cấy vi khuẩn đang nhận được sự chú ý đặc biệt. Đặc biệt, môi trường nuôi cấy vi khuẩn quyết định sự thành công của khi thực hiện theo phương pháp này. Hãy cùng Nhà thuốc Long Châu tìm hiểu trong bài viết dưới đây.
Nuôi cấy vi khuẩn là quá trình đưa mẫu nghi ngờ chứa vi khuẩn vào môi trường phù hợp để khuyến khích sự phát triển của chúng. Mục tiêu của quá trình này là để nhận biết các đặc điểm sinh hóa của vi khuẩn, từ đó đưa ra sơ bộ về nhóm hoặc loài vi khuẩn gây bệnh.
Có nhiều phương pháp nuôi cấy vi khuẩn, trong đó có: Cấy phân vùng bao gồm
Có nhiều loại môi trường nuôi cấy vi khuẩn phù hợp với các mục đích và loại bệnh phẩm khác nhau, cũng như đặc điểm cụ thể của từng vi khuẩn. Môi trường thạch rắn như thạch máu, thạch chocolate, thạch MacConkey và thạch UTI thường được sử dụng để nuôi cấy các vi khuẩn gây bệnh thông thường. Các phương pháp cấy phân vùng, cấy định lượng và bán định lượng thường sử dụng các loại thạch này.
Các loại thạch rắn còn được chọn lọc cho từng nhóm vi khuẩn cụ thể, ví dụ như thạch Strepto B cho nhóm Liên cầu nhóm B, thạch SS và Hektoen cho salmonella, shigella, và các loại vi khuẩn tương tự.
Đối với các vi khuẩn khó nuôi cấy hoặc có tính chất đặc biệt, cần sử dụng các môi trường đặc biệt như môi trường TCBS cho vi khuẩn tả.
Môi trường để nuôi cấy và tăng sinh thường là môi trường lỏng như BHI, canh thang glucose 2%, và môi trường pepton kiềm.
Môi trường nuôi cấy định danh có thể là môi trường thạch đặc trên đĩa petri hoặc thạch nghiêng, giúp phát hiện các tính chất sinh hóa của vi khuẩn và xác định tên chúng.

Mục đích: Phân lập vi khuẩn gây bệnh thành các cụm riêng biệt giúp chẩn đoán nguyên nhân gây bệnh.
Loại bệnh phẩm sử dụng: Các loại dịch (như dịch não tủy, dịch sinh dục), phân, mủ, vv.
Môi trường nuôi cấy vi khuẩn bao gồm: Blood Agar (thạch máu), Chocolate Agar (thạch Socola), TCBS, Macconkey,...
Quy trình thực hiện:
Lưu ý: Các đường cấy ở vùng sau cần chạm vào đường cấy ở vùng trước để đảm bảo sự phát triển của vi khuẩn ở tất cả các vùng và tạo ra các cụm riêng biệt.
Mục đích: Xác định số lượng vi khuẩn có khả năng phát triển trong một thể tích cụ thể của bệnh phẩm.
Loại bệnh phẩm thường được sử dụng: Nước tiểu.
Môi trường nuôi cấy: Thạch máu.
Quy trình:
Sau khi nuôi cấy, sự phát triển của vi khuẩn sẽ được theo dõi sau mỗi 24 giờ. Nếu vi khuẩn gây bệnh xuất hiện, sẽ tiến hành định danh bằng nhiều kỹ thuật khác nhau như dựa trên tính chất sinh vật hóa học cơ bản, sử dụng thanh API hoặc máy tự động. Mục tiêu là xác định chủng vi khuẩn gây bệnh và sau đó thực hiện kháng sinh đồ phù hợp.
Nếu không thấy sự xuất hiện của vi khuẩn gây bệnh sau 48 - 72 giờ, kết luận là kết quả nuôi cấy âm tính.

Những điều cần lưu ý khi bảo quản môi trường nuôi cấy vi khuẩn:

Trên đây là những thông tin về lựa chọn môi trường nuôi cấy vi khuẩn và cách bảo quản sau khi thực hiện. Hãy chia sẻ tới người thân, bạn bè nếu thấy bài viết hữu ích nhé!
Dược sĩ Đại họcNguyễn Mỹ Huyền
Dược sĩ Đại học có nhiều năm kinh nghiệm trong việc tư vấn Dược phẩm và hỗ trợ giải đáp thắc mắc về Bệnh học. Hiện đang là giảng viên cho Dược sĩ tại Nhà thuốc Long Châu.